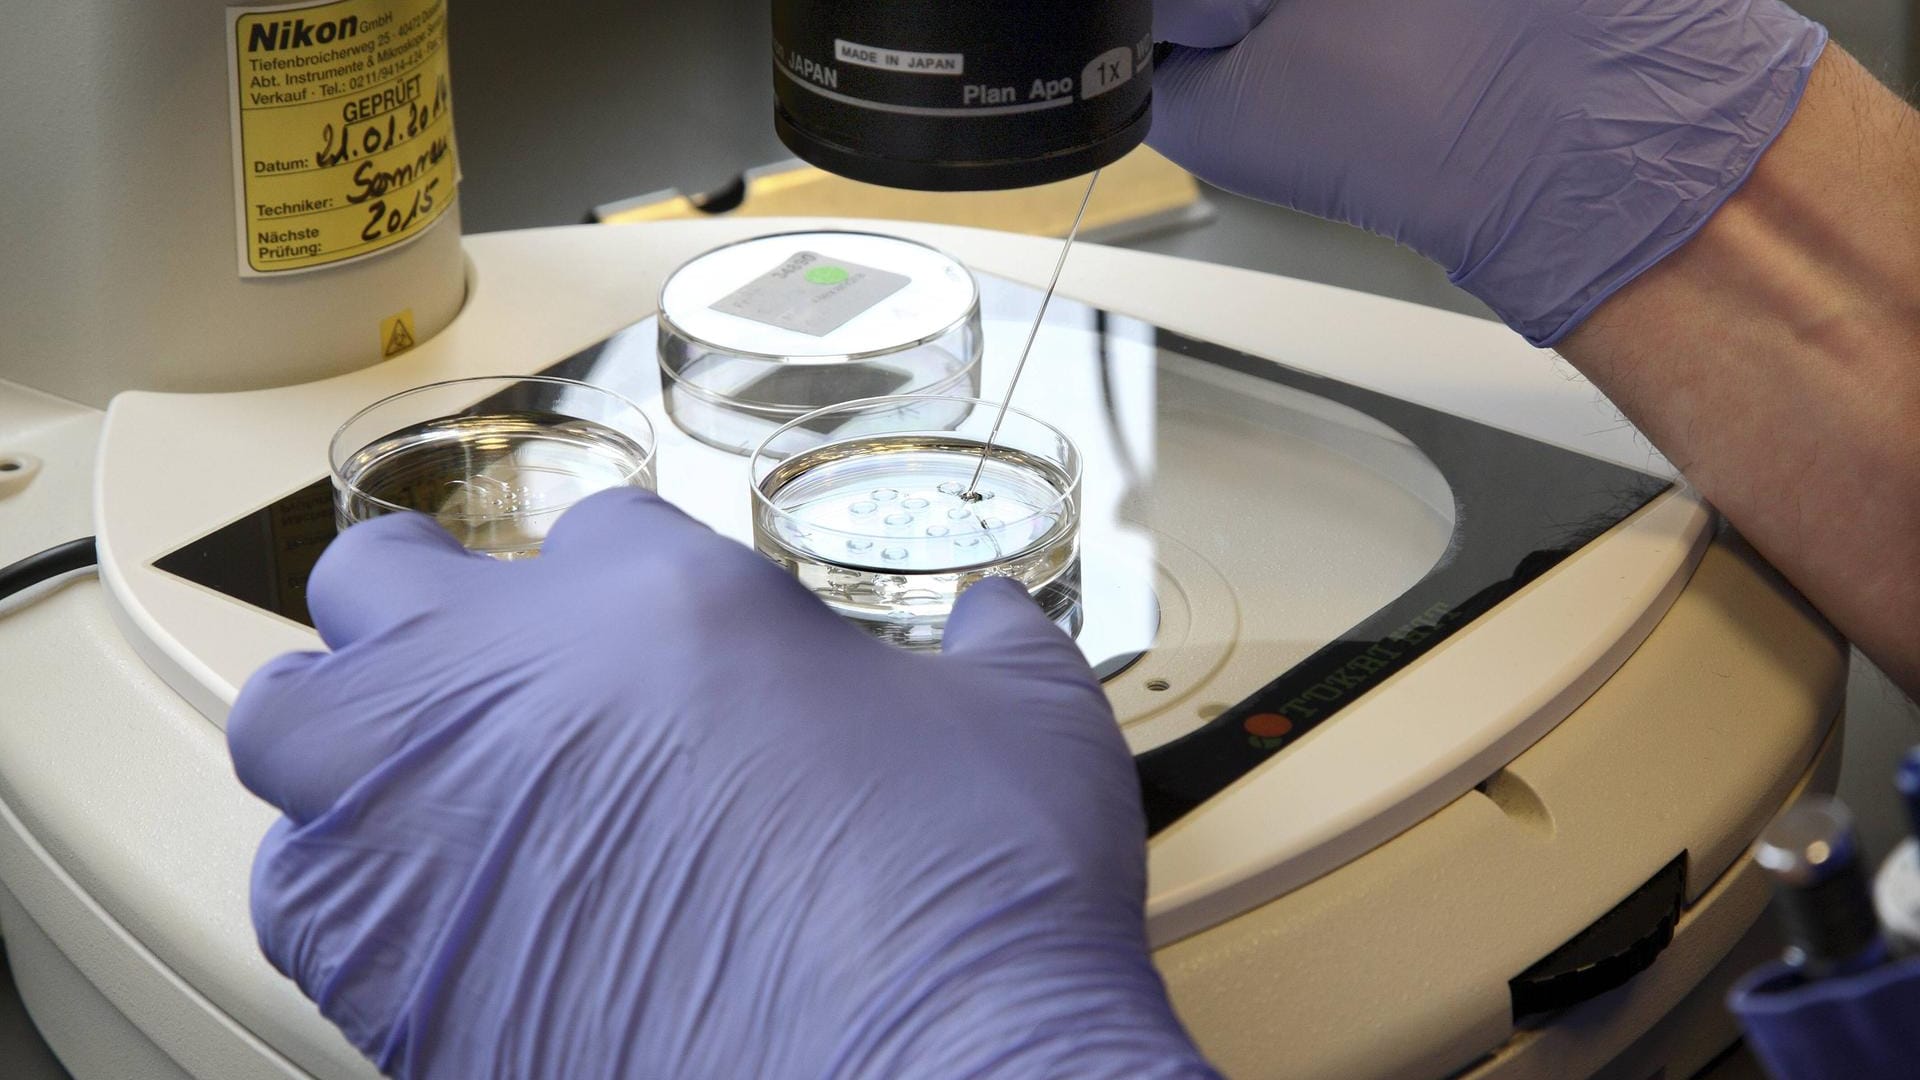

"Moralisch unakzeptabel" Gynäkologe zeugt 17 Kinder – ohne Wissen der Frauen
Ein Spezialist für künstliche Befruchtung hat in den Achzigerjahren Frauen mit seinem eigenen Sperma befruchtet. Der Fall wurde erst Jahre später durch Zufall geklärt.
Ein niederländischer Gynäkologe hat Patientinnen ohne deren Wissen mit seinem eigenen Sperma befruchtet und so mindestens 17 Kinder gezeugt. Der inzwischen gestorbene Arzt war an der Klinik in Zwolle zwischen 1981 und 1993 Spezialist für künstliche Befruchtungen mit Spender-Sperma. Das Isala-Krankenhaus in Zwolle, etwa 100 Kilometer östlich von Amsterdam, machte den Fall – auch im Namen der betroffenen Kinder – am Dienstag öffentlich. Das Verhalten des Arztes sei "moralisch unakzeptabel", erklärte die Klinik.
Kinder suchten nach biologischem Vater
Der Fall kam ans Licht, nachdem sich einige der heute erwachsenen Kinder unabhängig voneinander auf die Suche nach ihrem biologischen Vater begeben hatten. Die DNA-Proben der suchenden Kinder stimmten überein mit denen von anderen Suchenden – und auch mit der DNA-Probe eines Angehörigen des Arztes. So kam man auf den Namen des Mediziners.
Es wird nicht ausgeschlossen, dass der Mediziner noch mehr Kinder gezeugt hat. "Zur Zeit der Befruchtung in den 80er Jahren wurde den Wunscheltern geraten, die künstliche Befruchtung mit Spender-Samen zu verschweigen", heißt es in der Erklärung des Krankenhauses.
Vor einigen Jahren hatte ein ähnlicher Fall in den Niederlanden für Entsetzen gesorgt. Ein umstrittener Fortpflanzungsmediziner hatte in den 1980er und 1990er Jahren mit seinem Sperma mindestens 49 Kinder gezeugt. Auch in diesem Fall wussten die Eltern nichts davon.
- Nachrichtenagentur dpa